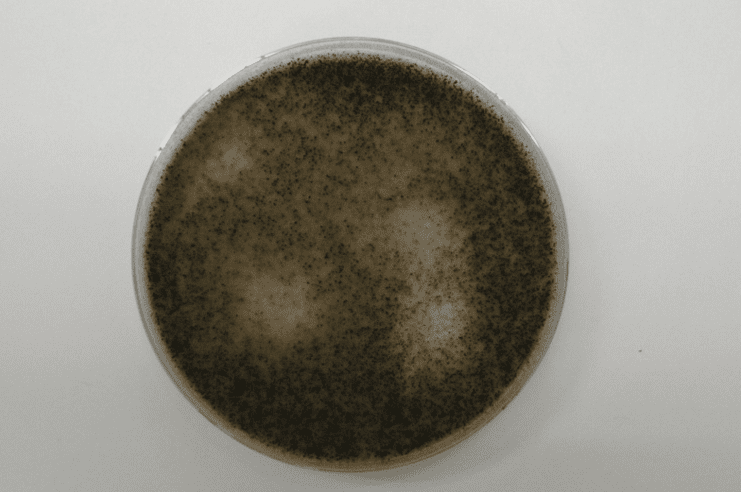
カビが生えたペトリ皿。白い背景に濃い黒色部分と明るい斑点が見えます。.
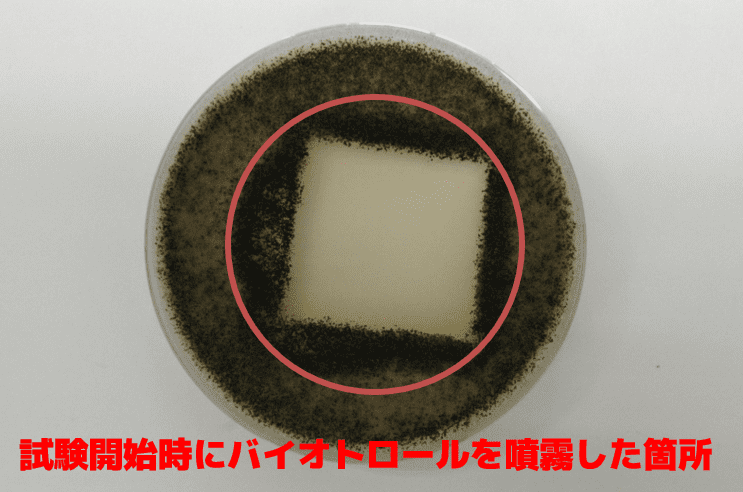
細菌の増殖を示すペトリ皿。中央に透明な正方形の領域がある。下部には「バイオトロールを噴霧した箇所」と日本語で書かれています。.

バイオトロールの特長
SUSTAIN
優れた除菌力に加え、
乾燥した後も効果(抗菌)が持続
漂白剤やアルコールの効果は濡れている間だけですが、バイオトロールは乾燥した後も効果が持続します。 目に見えないバリアを張り、数日間、環境によっては数ヶ月間、微生物を不活化させる効果を持ち続けます。 バイオトロールは、菌をやっつける力を持ちながら、人間やペット、植物には無害です。 病院や食品工場、農場など安全性と衛生的な環境を最も求められる現場でバイオトロールが使用されているのはそのためです。 (全ての菌、ウィルスに効果があるわけではありません。)
革新的な特許配合技術で
バイオトロールは生まれました
その成分について
バイオトロールは「塩化ベンザルコニウム」「ジデシルジモニウムクロリド」
「ポリヘキサメチレンビグアニド」「ジメチコン」を組み合わせる次世代の配合技術です。
それぞれの成分は目新しいものではありませんが、バイオトロールは“衛生革命を引き起こす”とまで言われています。
なぜでしょうか。
それはバイオトロールが従来の除菌剤では叶わなかった
「強力かつ持続可能な抗菌・除菌・抗ウィルス・防臭効果」を獲得したからです。
さらにバイオトロールには即効性もあり、芽胞(クロストリディオイデス・ディフィシル、セレウス)菌にさえも15〜60秒以内で除菌効果が認められました。

FEATURE
その特長
バイオトロールは、一般的に使用されているカチオン性殺菌剤と疎水性ポリマーに基づいた技術です。
バイオトロール技術の特長は、主にコロイド懸濁液内の殺生物剤成分の配列と構造化に因るものです。
その構造により、濡れた場所や乾燥した場所でも変わらずその除菌効果が最大限発揮されます。
アンフィセルの高分子構造により、懸濁液体中では浮遊微生物に対して 一度の接触で十分な除菌効果があります。
微生物は極めて小さな物です。
成分の化学作用だけを利用するのではなく、極小のものに多大な影響を及ぼす画期的なアンフィセルをバイオトロールは利用しています。
保護バリアの形成
除菌のメカニズム
01
マイナスに帯電している浮遊菌やウィルスは バイオトロールに引き付けられます。
02
バイオトロールに付着した細菌やウィルスには、上記針山のような表面により、四方八方に引っ張られる張力が発生します。
03
細菌やウィルスは張力に耐えられず引き裂かれ、分解されます。
ステファン・イェーツ教授率いるマンチェスター大学にあるthe Organic Materials Innovation Centre(OMIC)の研究チームによって バイオトロールに関するプロジェクトが立ち上げられました。
そして、バイオトロールが細菌などを除去するだけでなく、長時間持続するバリアを 形成することで、再度細菌が付着するのを防止することが明らかになりました。
原子間力顕微鏡で見たバイオトロール
針山のような表面で危険な微生物を破壊
バイオトロールによって形成される保護バリア表面は、針山のようになっています。
この鋭く尖った表面により、新たに付着しようとするバクテリアやウイルスを破壊し続けます。
バイオトロールと
他の成分との比較
この原子間力顕微鏡写真は、バイオトロールの表面分布を示しています。
乾いた後もこの構造はそのまま保たれます。
DETERGENCY
バイオトロールと次亜塩素酸の洗浄力比較
EN13697に基づく抗菌テスト
鉄板上の大腸菌【Campden BRIにより証明】
次亜塩素酸の場合は細菌が増殖していますが、バイオトロールは24時間後も保護効果が持続しています。
Campden BRIとは
英国最大の独立法人であり、世界的な研究開発を行う会員制の組織です。
Campden BRIとは
英国最大の独立法人であり、世界的な研究開発を行う会員制の組織です。
カビ抵抗性試験検査画像
〈Jis z 2911に準じたカビ抵抗性試験B法〉
28日経過後
28日経過後

シャーレでカビ5種(コウジカビ、アオカビ、ケタマカビ、クロカビ、黒酵母) を培養し、28日間経過後の発生状況を撮影した画像。
バイオトロールを噴霧した箇所は抗菌持続性の効果を発揮し、カビの発生が見られませんでした。
試験依頼先:一般社団法人京都微生物研究所
除菌剤性能比較表
バイオトロールの特長の一つに基材への損傷性が極めて低い事があげられます。
基材によって除菌剤を変える必要がないので、あらゆる環境の清拭を
バイオトロール1本にまとめてしまう事が可能となります。
バイオトロールの特徴の一つに基材への
損傷性が極めて低い事があげられます。
基材によって除菌剤を変える必要がないので、
あらゆる環境の清拭をバイオトロール1本に
まとめてしまう事が可能となります。
← 表は左右に動かせます →
|
|
バイオトロール |
アルコール |
次亜塩素酸ナトリウム |
二酸化塩素 |
|
属性 |
中性 |
中性 |
アルカリ性 |
酸性 |
|
除菌効果
|
即効性 |
◎ |
◎ |
◎ |
◎ |
| 持続性 |
◎ |
× |
× |
× |
|
安全性
|
ゴム |
◎ |
○ |
× |
△ |
| 金属 |
○(要防水加工) |
○ |
× |
× |
| アルミニウム |
◎ |
○ |
× |
× |
| ステンレス |
◎ |
○ |
× |
× |
| プラスチック |
◎ |
○ |
× |
× |
| ABS 樹脂 |
◎ |
× |
× |
× |
| 皮革 |
◎ |
× |
× |
× |
| 布 |
◎ |
○ |
× |
× |
| 非漂白性 |
◎ |
◎ |
× |
× |
| 非可燃性 |
◎ |
× |
◎ |
◎ |
| 有毒ガス非発生 |
◎ |
○ |
× |
× |
| 無刺激 |
◎ |
× |
× |
△ |
| 無臭性 |
◎ |
× |
× |
△ |
| 無揮発 |
◎ |
× |
× |
× |
| 安全性 |
◎ |
△ |
× |
× |
| 保存期間 |
◎ |
× |
○ |
× |
EXAMINATION
バイオトロール腐食試験表
様々な金属、 非金属に対する除菌液の腐食性試験
依頼研究所名 : ENSPEC Technology UK
試験法 : ASTM G31

試験方法
① 試料 2 種 上段 : バイオトロール 下段 : 他社次亜塩素酸ナトリウム 1,000ppm
② ステンレス、 アルミニウム、 ウレタンマットカバー、 ポリカーボネート各素材の点線部分 (下部) まで①の薬液を浸漬し 7 日後 ・ 28 日後 ・ 154 日経過後の状態を確認する。
PATENT
世界各国での特許取得状況
← 表は左右に動かせます →
|
国
|
タイトル
|
登録番号
|
 ブラジル ブラジル
|
Anti-Microbial Composition
|
PI0814611.0
|
 カナダ カナダ
|
Anti-Microbial Composition
|
2699696
|
 南アフリカ 南アフリカ
|
Anti-Microbial Composition
|
2010/01882
|
 米国 米国
|
Anti-Microbial Composition
|
8598106
|
 日本 日本
|
Anti-Microbial Composition
|
5615708
|
 メキシコ メキシコ
|
Anti-Microbial Composition
|
297322
|
 中国 中国
|
Anti-Microbial Composition
|
109561694
|
 ヨーロッパ ヨーロッパ
|
Anti-Microbial Composition
|
3500102
|
 インドネシア インドネシア
|
Anti-Microbial Composition
|
2019/06096 / IDP000079198
|
 インド インド
|
Anti-Microbial Composition
|
382535
|
 シンガポール シンガポール
|
Anti-Microbial Composition
|
11201901257V
|
 タイ タイ
|
Anti-Microbial Composition
|
1901000934
|
 香港 香港
|
Anti-Microbial Composition
|
40007842
|

ブラジル
ブラジル
 カナダ
カナダ
 南アフリカ
南アフリカ
 米国
米国
 日本
日本
 メキシコ
メキシコ
 中国
中国
 インドネシア
インドネシア
 インド
インド
 シンガポール
シンガポール
 タイ
タイ
 香港
香港
